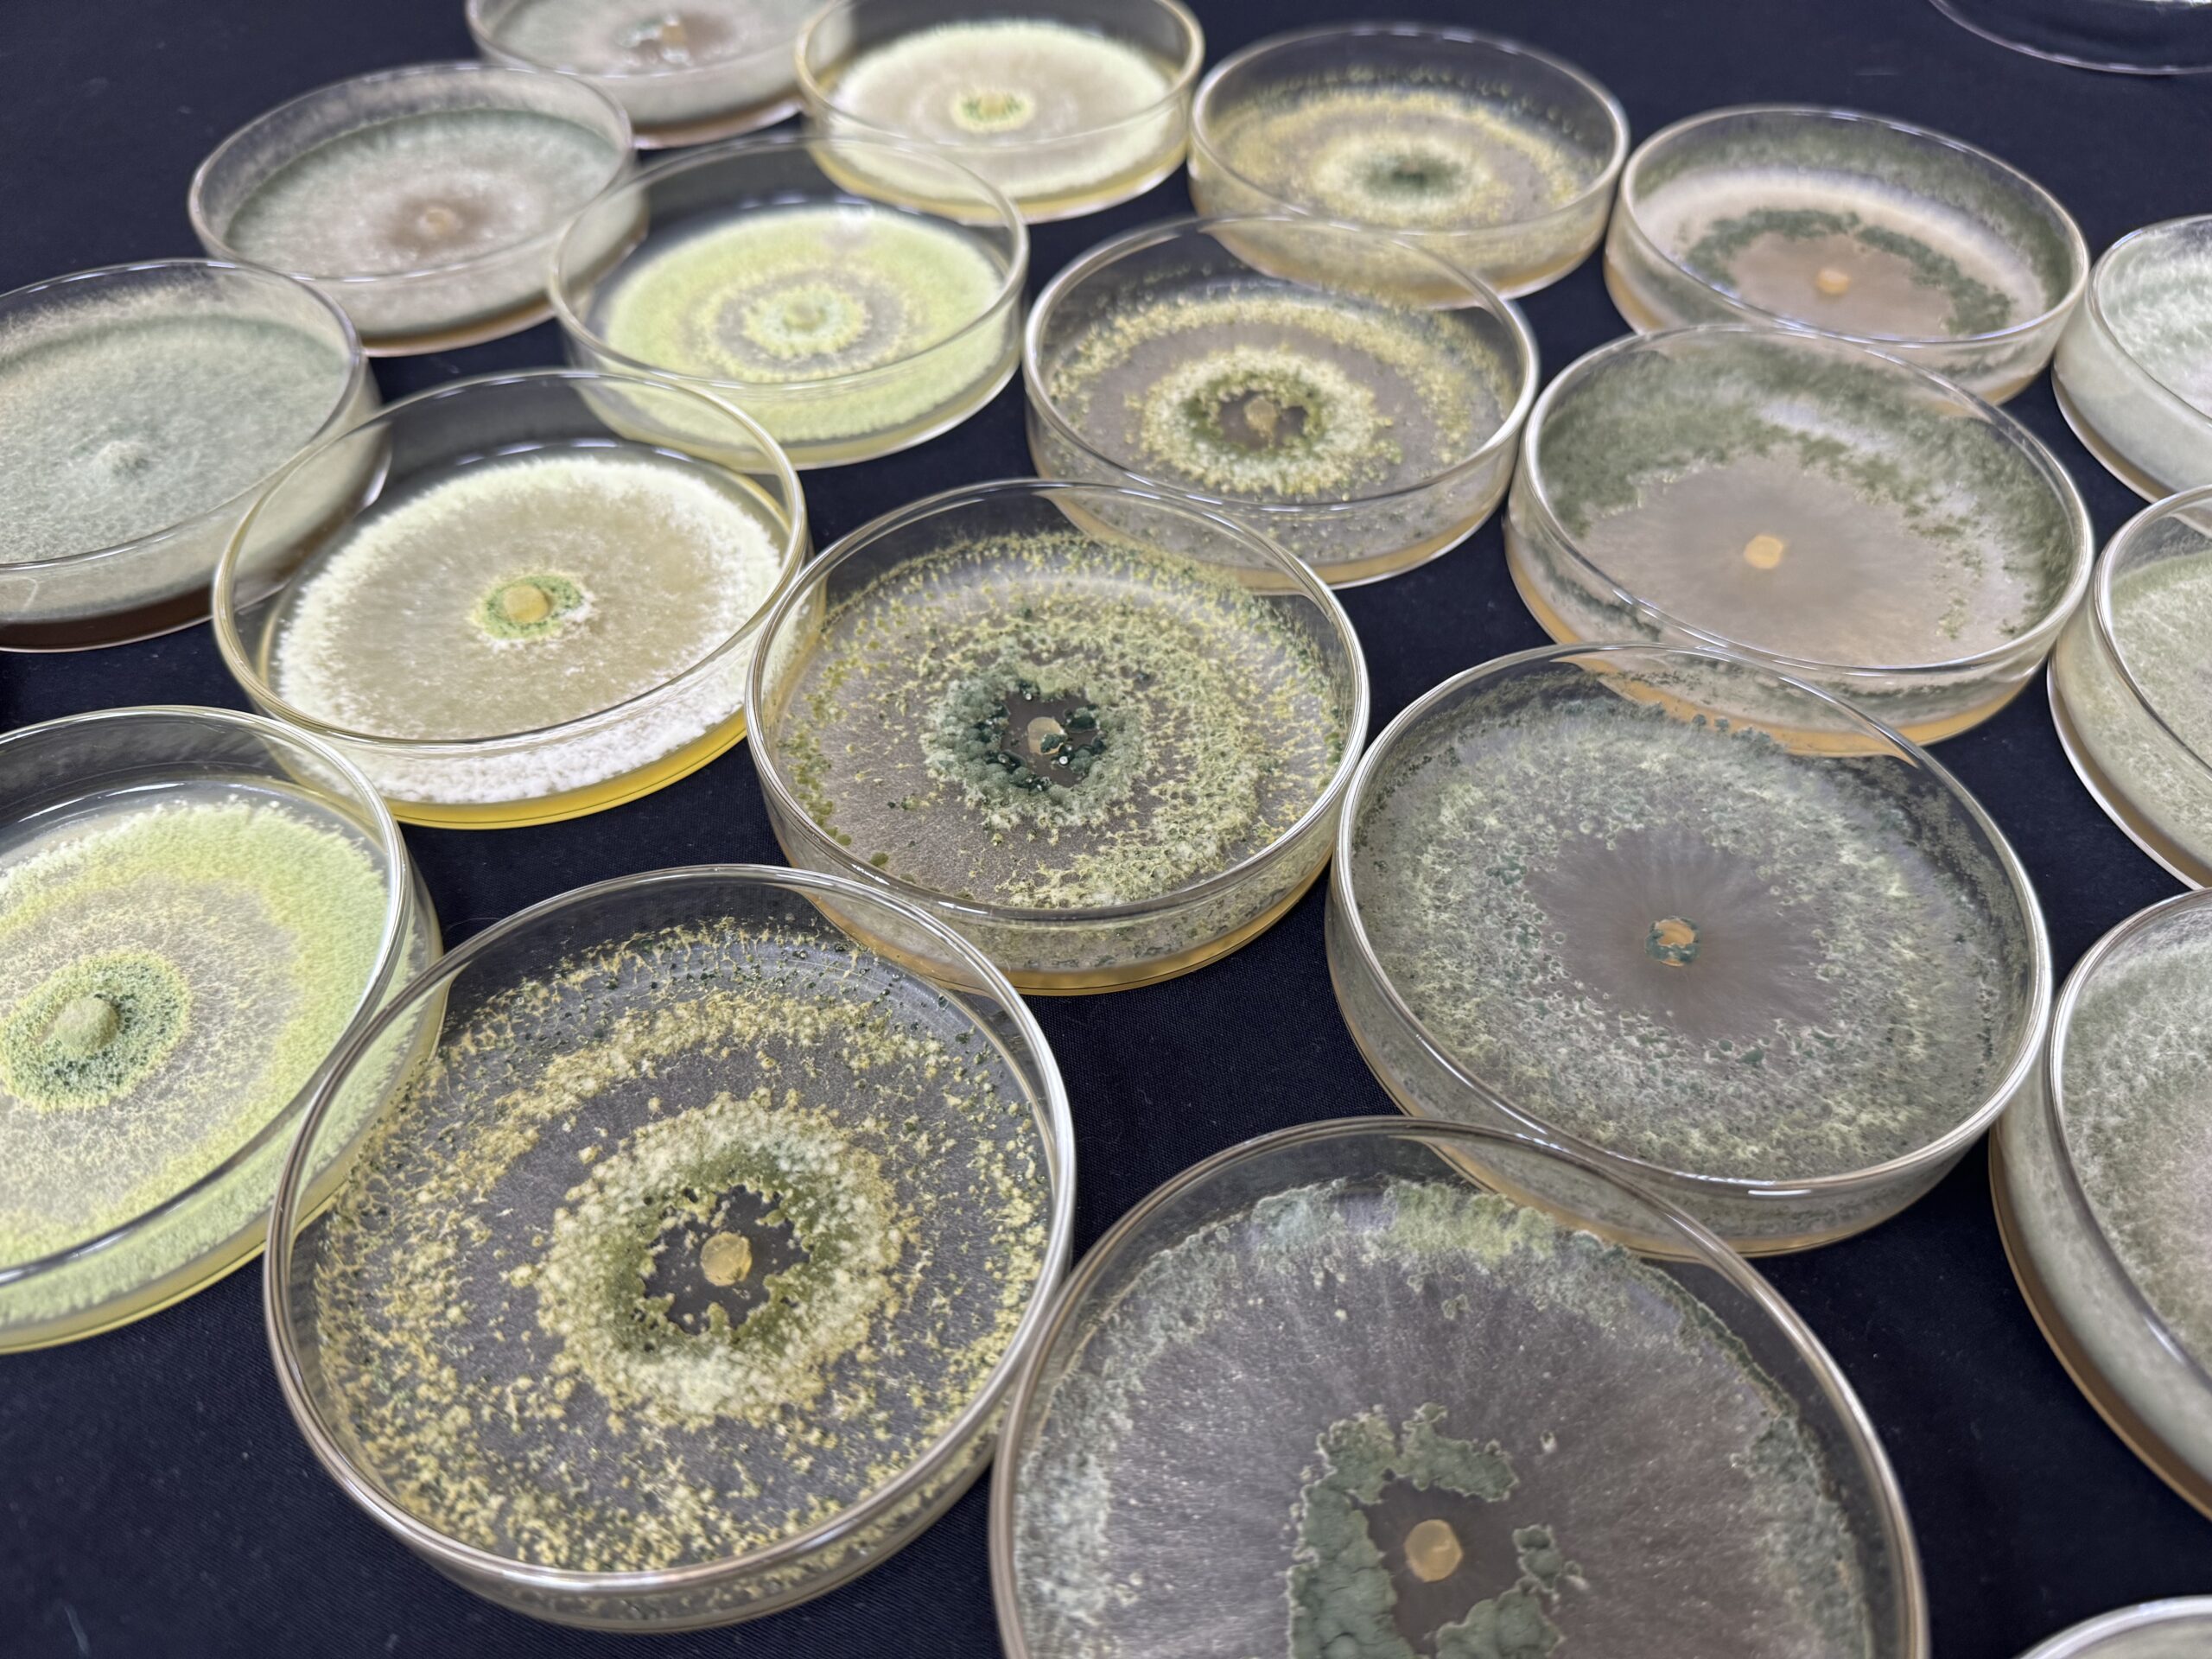

Laboratorios BRGM
BRGM cuenta con cuatro modernos laboratorios, en los que se lleva a cabo tanto investigación como valorización de los microorganismos conservados en la CChRGM, transformando recursos genéticos en soluciones biotecnológicas aplicadas para la agricultura chilena e internacional.
Colección Chilena de Recursos Genéticos Microbianos
¿Cómo funciona la CChRGM?
La Colección Chilena de Recursos Genéticos Microbianos (CChRGM) recibe depósitos de microorganismos a través de dos unidades especializadas.
Laboratorio de Procesamiento Primario de Muestras (LPP)
Laboratorio de Conservación (LC)
Juntas, estas unidades llevan a cabo el proceso completo de depósito, desde la recepción del material biológico hasta su almacenamiento a largo plazo. En el LPP, las cepas son recibidas, codificadas de manera temporal y revisadas en su pureza bajo lupas y microscopios. En el LC se realiza el almacenamiento de los microorganismos bajo condiciones controladas mediante criogenia y liofilización y se llevan a cabo las pruebas de viabilidad y pureza post-preservación.
El equipo humano de la colección está compuesto por profesionales y técnicos con sólida formación en microbiología, taxonomía microbiana, conservación por congelación y liofilización, identificación molecular y microscopía, asegurando altos estándares de calidad en cada etapa del proceso.
Las cepas que ingresan a la CChRGM pueden ser depositadas bajo distintas modalidades: depósito público, privado o para fines de patentamiento. Por otro lado, las cepas colectadas internamente en proyectos ejecutados por el INIA, en tanto, se conservan en colecciones de trabajo, orientadas a investigación y desarrollo de soluciones biotecnológicas para la agricultura.
Para garantizar su estabilidad en el tiempo, las cepas son almacenadas en tres sistemas de respaldo complementarios:
Ultra-congelador a -150 °C
Tanque de nitrógeno líquido a -190 °C
Liofilización en ampollas de vidrio

Laboratorio de Identificación Molecular (LIM) del Banco de Recursos Genéticos Microbianos
Identificación precisa para la conservación y uso seguro de microorganismos
El Laboratorio de Identificación Molecular (LIM) de la CChRGM cumple un rol clave en la caracterización y confirmación de microorganismos mediante técnicas de biología molecular. Su labor se centra en la identificación de cepas bacterianas, fúngicas y levaduras, tanto del material depositado en la colección como de muestras provenientes de instituciones externas. A través de metodologías como PCR convencional y PCR en tiempo real (qPCR), el LIM realiza análisis a nivel de género y especie, permitiendo validar la identidad taxonómica de las cepas conservadas, así como detectar fitopatógenos directamente en tejidos vegetales.
El laboratorio presta apoyo tanto a la investigación interna del INIA como a servicios externos para universidades, centros de investigación y empresas del ámbito agrícola y biotecnológico. Esta unidad no solo fortalece la calidad científica de la colección, sino que también asegura trazabilidad y precisión en los procesos de conservación y uso de los recursos microbianos.
Laboratorio de Microbiología Aplicada (LMA)
Diagnóstico fitopatológico de precisión para la salud de los cultivos
En el LMA del Banco de Recursos Genéticos Microbianos, se realiza el diagnóstico de enfermedades en plantas mediante la evaluación de síntomas visibles, signos de infecciones bacterianas y fúngicas y otras alteraciones de origen fisiológico o abiótico. Este servicio está disponible para toda la comunidad: agricultores, empresas, instituciones de investigación, universidades y público general.
El diagnóstico se basa principalmente en técnicas microbiológicas clásicas, como cámaras húmedas, cultivos en agua y siembras en medios de cultivo específicos, que permiten detectar e identificar hongos y bacterias fitopatógenas a partir del tejido vegetal afectado.
Cuando se trata de cepas de especial relevancia, por su agresividad, distribución inusual o posible novedad, se complementa con identificación molecular y, si corresponde, se aplican los postulados de Koch para confirmar la patogenicidad. En casos que representen un primer reporte en Chile, se informa oficialmente al Servicio Agrícola y Ganadero (SAG).

Los resultados se entregan en un informe técnico que incluye el nombre del patógeno identificado (a nivel de género o especie, según el caso), su comportamiento habitual en el cultivo y zonas donde ha sido reportado. No se recomienda un producto específico, pero se entrega información útil para la toma de decisiones agronómicas.
El proceso de diagnóstico tiene una duración promedio de 7 a 10 días, lo que considera la recepción de la muestra, el aislamiento del microorganismo, el análisis microbiológico y la elaboración del informe.
Laboratorio de bioprocesos (LBP)
Realizamos investigación para desarrollar soluciones basadas en microorganismos benéficos
El Laboratorio de Bioprocesos (LBP) del BRGM tiene como misión valorizar los recursos genéticos microbianos mediante el desarrollo de soluciones biotecnológicas innovadoras que respondan a los desafíos del sector agrícola. Para ello, desarrolla bioinsumos a partir de cepas conservadas en la CChRGM.
El laboratorio se especializa en el diseño de protocolos para la masificación, formulación y aplicación de bioinsumos basados en microorganismos benéficos como bacterias, hongos filamentosos y levaduras, con impacto tanto en la agricultura familiar campesina como en agrícolas de mayor tamaño.
El LBP ofrece servicios de calidad para bioinsumos, incluyendo análisis de viabilidad, pureza y conteo de unidades formadoras de colonias (UFC). Además, trabaja con todo tipo de formulaciones, desde líquidas hasta sólidas, adaptándose a las necesidades específicas de cada proyecto.
Entre los sectores beneficiados con estas tecnologías destacan cultivos frutales, y hortalizas, generando soluciones sostenibles que aportan al desarrollo de una agricultura más resiliente.
